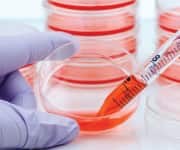
Stem Cell Research

Life Extension Magazine®
Stem cells continuously replenish and repair many body tissues.

Red blood cells are replenished about every four months, skin cells are replenished in less than a month, and cells lining the small intestine are replaced every few days. The stem cells performing this function are called somatic stem cells. Somatic stem cells are important contributors to wound healing.1 The decline in somatic cell function with age might be one of the reasons why wounds heal more slowly, and with more scarring, as people grow older.2
Somatic stem cells usually are only capable of becoming the type of cell found in the tissue where they reside. Some stem cells are multipotent, capable of differentiating into many types of cells. Notable examples include hematopoietic stem cells (HSCs) which can become any type of blood cell (red blood cells, white blood cells, or other immune-system cells) and mesenchymal stem cells (MSCs), which can differentiate into bone cells, fat cells, muscle cells, or cartilage cells.3,4
Stem Cell Transplants
HSC transplantation has been performed for decades, but only for life-threatening conditions. Chemotherapy or radiation therapy against cancer can destroy bone marrow immune cells. So HSCs can be extracted from a patient before therapy and replaced after therapy. Often, however, it is necessary to use stem cells from another person, matched as closely as possible with compatible human leukocyte antigens (HLAs). Many different HLA proteins occur on the surface of cells, which vary considerably from person to person, and which are the major cause of immune system rejection associated with organs or tissues transplanted from one person to another. Even when well-HLA-matched sibling tissues are used, drugs to suppress the immune system are required.5
Regenerative Medicine
A dream of stem cell therapy is to only use stem cells that are HLA-compatible with the body tissue of the patient to prevent immune rejection, and to avoid the need to use drugs to suppress the immune system. Only stem cells that originate from the body of the patient receiving the treatment would fulfill that requirement. Such stem cells would be essential for regenerative medicine, allowing for the replacement or repair of any defective tissue or organ.

Embryonic stem cells (ESCs) isolated from a patient can differentiate into any type of cell needed by the patient (pluripotent). In 1998, human ESCs were first derived from human embryos only a few days old, but only by destroying the embryo.6 In 2006, however, a method was found to remove an ESC from an embryo without destroying the embryo.7 But that same year, Japanese researcher Shinya Yamanaka discovered a way of inducing mouse skin cells to become pluripotent as ESCs.8 The following year he was able to create similar induced pluripotent stem cells (iPSCs) from human skin cells.9 For these achievements, Dr. Yamanaka together with Sir John B. Gurdon won a Nobel Prize in 2012.
Much work remains to be done, however, to fulfill the hope that iPSCs represent. Human iPSCs take weeks to derive, efficiency is often as low as 0.1% and quality is often poor.10-12 Differentiating somatic cells from iPSCs is far from an exact science. Despite being derived from the patient for whom they are to be used, iPSCs can often produce an immune response due to poor quality.13 iPSCs become cancerous much more often than ESCs.14
Urgent Need to Accelerate Stem Cell Research
Although many scientists believe pluripotent stem cells (ESCs and iPSCs) hold great potential for regenerative medicine, it will probably be at least a decade before technologies are developed to safely and effectively expand and differentiate them.
iPSCs are the most promising source of patient-specific pluripotent stem cells, yet iPSCs have many more genetic abnormalities than ESCs, and about ten times more mutations than the cells from which they were derived.15,16
It is essential to expand the number of stem cells in order to have sufficient quantity of those cells for therapy, but iPSCs are far more difficult than ESCs to expand without defects.16 It is likely that technologies developed in the coming decade will help overcome these limitations.
Fetal tissue is rich in stem cells, and those stem cells have a low risk of immune system rejection because HLA immaturity protects the fetus from immune rejection by the mother. Although fetal tissue has been used to treat a wide variety of diseases, low availability and ethical concerns constrain its use.17 Stem cells from umbilical cord blood have similar advantages, but also have limited availability.18
Hematopoietic Stem Cells (HSCs) are the most commonly used curative stem cell therapy in modern medicine,19 but MSCs are by far the most common type being tested in clinical trials.20 MSCs can be used without HLA matching because MSCs do not express a broad class of HLA antigens.21 Moreover, MSCs possess many anti-inflammatory properties, so MSCs have often been used to suppress the immune system after organ transplantation.22 Although MSCs were originally derived from bone marrow, MSCs can now be derived from a wide variety of tissues and body fluids.23 The main benefit of MSCs is their ability to enhance the repair capabilities of tissues, rather than their ability to engraft (which is poor).24 A major challenge with MSCs is their wide cell-to-cell variability.25
Parabiosis experiments which connect the circulatory systems of genetically matched young and old mice have been shown to restore somatic stem cell function in the old mice.26 The Life Extension Foundation® is seeking to raise funds for clinical trials with the hope of reversing frailty in elderly humans who are given extracts of young blood.
Technical Report Available On-line
I’ve written a technical report describing presentations made at recent stem cell conferences I’ve attended on behalf of Life Extension Foundation.
Most notable were data presented at a conference organized by Nobel Laureate Shinya Yamanaka at Kyoto University in Kyoto, Japan, held March 22-24, 2016.
If you have any questions on the scientific content of this article, please call a Life Extension® Wellness Specialist at 1-866-864-3027.
References
- Chen M, Przyborowski M, Berthiaume F. Stem cells for skin tissue engineering and wound healing. Crit Rev Biomed Eng. 2009;37(4-5):399-421.
- Sgonc R, Gruber J. Age-related aspects of cutaneous wound healing: a mini-review. Gerontology. 2013;59(2):159-64.
- Kohli L, Passegue E. Surviving change: the metabolic journey of hematopoietic stem cells. Trends Cell Biol. 2014;24(8):479-87.
- Available at: http://stemcells.nih.gov/info/basics/4.htm. Accessed August 24, 2016.
- Urayama KY, Thompson PD, Taylor M, et al. Genetic variation in the extended major histocompatibility complex and susceptibility to childhood acute lymphoblastic leukemia: a review of the evidence. Front Oncol. 2013;3:300.
- Thomson JA, Itskovitz-Eldor J, Shapiro SS, et al. Embryonic stem cell lines derived from human blastocysts. Science. 1998;282(5391):1145-7.
- Klimanskaya I, Chung Y, Becker S, et al. Human embryonic stem cell lines derived from single blastomeres. Nature. 2006;444(7118):481-5.
- Takahashi K, Yamanaka S. Induction of pluripotent stem cells from mouse embryonic and adult fibroblast cultures by defined factors. Cell. 2006;126(4):663-76.
- Takahashi K, Tanabe K, Ohnuki M, et al. Induction of pluripotent stem cells from adult human fibroblasts by defined factors. Cell. 2007;131(5):861-72.
- Sebban S, Buganim Y. Nuclear Reprogramming by Defined Factors: Quantity Versus Quality. Trends Cell Biol. 2016;26(1):65-75.
- Wang J, Gu Q, Hao J, et al. Generation of induced pluripotent stem cells with high efficiency from human umbilical cord blood mononuclear cells. Genomics Proteomics Bioinformatics. 2013;11(5):304-11.
- Stadtfeld M, Hochedlinger K. Induced pluripotency: history, mechanisms, and applications. Genes Dev. 2010;24(20):2239-63.
- Zhao T, Zhang ZN, Rong Z, et al. Immunogenicity of induced pluripotent stem cells. Nature. 2011;474(7350):212-5.
- Gutierrez-Aranda I, Ramos-Mejia V, Bueno C, et al. Human induced pluripotent stem cells develop teratoma more efficiently and faster than human embryonic stem cells regardless the site of injection. Stem Cells. 2010;28(9):1568-70.
- Pera MF. Stem cells: The dark side of induced pluripotency. Nature. 2011;471(7336):46-7.
- Hussein SM, Batada NN, Vuoristo S, et al. Copy number variation and selection during reprogramming to pluripotency. Nature. 2011;471(7336):58-62.
- Ishii T, Eto K. Fetal stem cell transplantation: Past, present, and future. World J Stem Cells. 2014;6(4):404-20.
- Ruggeri A, Paviglianiti A, Gluckman E, et al. Impact of HLA in cord blood transplantation outcomes. Hla. 2016;87(6):413-21.
- Pineault N, Abu-Khader A. Advances in umbilical cord blood stem cell expansion and clinical translation. Exp Hematol. 2015;43(7):498-513.
- Trounson A, McDonald C. Stem Cell Therapies in Clinical Trials: Progress and Challenges. Cell Stem Cell. 2015;17(1):11-22.
- Olson AL, McNiece IK. Novel clinical uses for cord blood derived mesenchymal stromal cells. Cytotherapy. 2015;17(6):796-802.
- Kim N, Cho SG. New strategies for overcoming limitations of mesenchymal stem cell-based immune modulation. Int J Stem Cells. 2015;8(1):54-68.
- Liu S, Zhou J, Zhang X, et al. Strategies to Optimize Adult Stem Cell Therapy for Tissue Regeneration. Int J Mol Sci. 2016;17(6).
- Dulamea AO. The potential use of mesenchymal stem cells in stroke therapy--From bench to bedside. J Neurol Sci. 2015;352(1-2):1-11.
- Li Z, Zhang C, Weiner LP, et al. Molecular characterization of heterogeneous mesenchymal stem cells with single-cell transcriptomes. Biotechnol Adv. 2013;31(2):312-7.
- Scudellari M. Ageing research: Blood to blood. Nature. 2015;517(7535):426-9.

